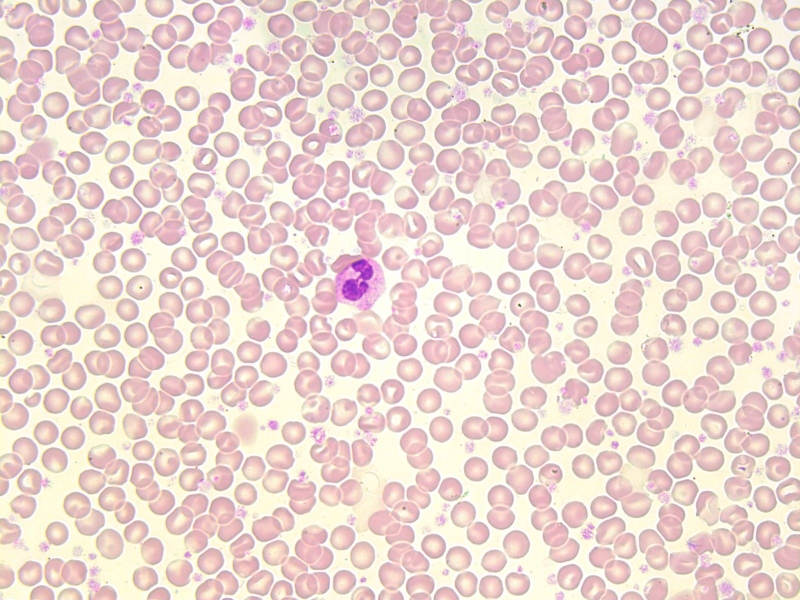
Mono là gì Xét nghiệm bạch cầu mono có ý nghĩa gì 2

21/08/2025
Mặc định
Lớn hơn
Khi nhận được kết quả xét nghiệm máu, chắc hẳn bạn đã từng thấy chỉ số bạch cầu mono có trong máu hiển thị trên bản kết quả. Vậy bạch cầu mono là gì? Chỉ số xét nghiệm bạch cầu mono dùng để làm gì? Cùng tham khảo ngay dưới đây nhé.
Bạch cầu mono là một trong những xét nghiệm quan trọng khi làm xét nghiệm máu. Chỉ số mono tăng hay giảm đều mang ý nghĩa nhất định đối với sức khỏe cũng như thể trạng của người bệnh.
Trong những thành phần quan trọng hình thành nên máu người, không thể thiếu đi những bạch cầu với chức năng chính là làm nhiệm vụ tìm kiếm, phát hiện và tiêu diệt những yếu tố lạ khi xâm nhập và hệ tuần hoàn, cụ thể hơn là dòng chảy của máu.
Những yếu tố, tác nhân gây bệnh như vi khuẩn, những tác nhân gây hại cho tế bào và có khả năng làm suy giảm miễn dịch đều có khả năng xuất hiện trong máu người, chính vì thế mà sự có mặt của bạch cầu giúp kiểm soát tốt hơn dấu hiệu xâm nhập, với mỗi loại bạch cầu là một chức năng cụ thể khác nhau.

Bạch cầu mono có cấu tạo gần như trong suốt
Vậy bạch cầu mono là gì? Bạch cầu mono là một tế bào bạch cầu quan trọng trong máu người, trong suốt và gần như không có màu sắc. Nhiệm vụ chính của bạch cầu mono là gì? Bạch cầu mono đảm nhận nhiệm vụ chính là bảo vệ cơ thể cũng như các tế bào hồng cầu khỏi sự tấn công của các mầm bệnh xâm nhập vào máu.
Ngoài có mặt trong máu người thì bạch cầu mono còn xuất hiện ở một số bộ phận cơ thể khác như lách, mạch bạch huyết hoặc trong hệ thống các mạch cũng có sự xuất hiện của loại bạch cầu đặc biệt này.
Thời gian lưu hành bạch cầu mono là gì? Ngoài lưu hành trong máu, bạch cầu mono còn lưu hành trong các bộ phận cơ thể khác với thời gian cụ thể như sau:
Phân loại bạch cầu mono gồm có 3 loại chính, mỗi loại có đặc điểm về chức năng và nhiệm vụ khác nhau, trong đó gồm có:
Việc thực hiện xét nghiệm bạch cầu mono là gì đóng vai trò tương đối quan trọng với việc phản ánh khả năng miễn dịch của cơ thể trước các mầm bệnh xâm nhập từ bên ngoài, thông qua đó cho thấy tình trạng sức khỏe cụ thể của người bệnh.
Mặc dù chỉ số bạch cầu mono có thể hiện trong bảng phân tích kết quả xét nghiệm máu nhưng điều này chưa thể hiện được chính xác nhất tình trạng bạch cầu mono hiện tại. Vì vậy mà khi nhận định có vấn đề, bác sĩ sẽ chỉ định thực hiện xét nghiệm bạch cầu mono riêng biệt để kết quả phân tích cụ thể, chính xác, rõ ràng hơn.
Xét nghiệm bạch cầu mono giúp nhận định số lượng bạch cầu trong máu
Thực hiện xét nghiệm bạch cầu mono là gì? Đây thực chất là quá trình tiến hành đo đạc số lượng bạch cầu mono có trong máu, dựa trên con số này có thể nhận định được tình trạng bạch cầu mono có bình thường, ổn định không hay đang gặp vấn đề tăng quá nhanh hoặc giảm quá mạnh, từ đó chẩn đoán nguyên nhân và tìm ra bệnh lý khiến số lượng bạch cầu mono biến đổi.
Ngoài nguyên nhân do bệnh lý hoặc vấn đề sức khỏe cụ thể thì một số loại thuốc uống kê đơn cũng là số lượng bạch cầu mono bị ảnh hưởng, có thể tăng hoặc giảm tùy vào loại thuốc bệnh nhân đang uống. Do vậy nên khi thực hiện xét nghiệm bạch cầu mono, bạn cần chủ động trao đổi với bác sĩ về tình trạng sức khỏe hiện tại, loại thuốc đang uống hoặc bệnh đang gặp phải để bác sĩ rõ hơn về tình trạng bệnh nhân và cho kết quả chẩn đoán chính xác nhất.
Ngoài thắc mắc bạch cầu mono là gì thì xét nghiệm bạch cầu mono để làm gì, có ý nghĩa gì cũng được nhiều người quan tâm không kém. Theo giải đáp từ các chuyên gia và bác sĩ chuyên môn, xét nghiệm cho thấy số lượng bạch cầu mono cụ thể, có dấu hiệu tăng hay giảm và dùng để chẩn đoán bệnh lý.
Nếu số lượng bạch cầu mono trong máu tăng có thể do những bệnh lý sau:
Ngược lại, nếu kết quả xét nghiệm bạch cầu mono giảm, có thể là triệu chứng những bệnh lý như:

Số lượng bạch cầu mono giảm cho thấy sức đề kháng sụt giảm
Những thông tin trên cho thấy việc thực hiện xét nghiệm bạch cầu mono là vô cùng cần thiết, là yếu tố quan trọng trong chẩn đoán và khoanh vùng bệnh lý, nhận định vấn đề sớm hơn và có cách, phương hướng điều trị hiệu quả hơn. Nếu nhận thấy bản thân có dấu hiệu sụt giảm miễn dịch, dễ đau ốm hơn bình thường, bạn nên đến bệnh viện để kiểm tra sức khỏe và thực hiện xét nghiệm bạch cầu mono theo chỉ định của bác sĩ chuyên môn nhé.
Hy vọng những thông tin vừa được chia sẻ trên đây đã giúp bạn giải đáp thắc mắc mono là gì, bạch cầu mono là gì. Để biết chính xác hơn về chỉ số bạch cầu mono của mình có bình thường, ổn định hay không, bạn nên đến bệnh viện uy tín để thực hiện xét nghiệm bạch cầu mono.
Hồng Nhung
Nguồn tham khảo: Tổng hợp